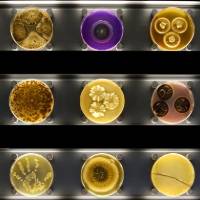
Micropia

Receive for Free - Discover & Explore eNewsletter monthly with advance notice of special offers, packages, and insider savings from 10% - 30% off Best Available Rates at selected hotels.
location
Many landmarks within the city are close to the hotel, making The Grand Amsterdam an ideal starting point for exploring the city. Guests can learn about Dutch history by visiting the Royal Palace, the Anne Frank House, and the exhibits at De Nieuwe Kerk. The historical shopping centers at De Negen Straatjes and the Fashion and Museum District are perfect for guests who want to purchase exquisite Dutch goods. The nearby Vondelpark provides guests a wonderful nature hideaway, should they wish to briefly escape from Amsterdam’s vibrant crowds. And with Airport Schiphol only a few kilometers away, Sofitel Legend The Grand Amsterdam offers guests a convenient location to begin their journey into this historical city.
Nearest Airport
Amsterdam Airport Schiphol (AMS): 12.5 mi/20 km, 25 minutes
Hotel Address
Oudezijds Voorburgwal 197, Amsterdam
Netherlands 1012 EX
Historic Hotels Worldwide Recommended Points of Interest
-

A'DAM Lookout
Experience unrivaled views of downtown Amsterdam from the A'DAM Lookout.
-

ARTIS
Explore the wide variety of animals at ARTIS.
-

Allard Pierson Museum
Discover artifacts from ancient Greece, Rome, and Egypt at the Allard Pierson Museum.
-

Amsterdam Cheese Museum
Explore Amsterdam's culinary heritage with cheese at this impressive cultural destination.
-

Amsterdam Museum
Experience the city's storied past at the Amsterdam Museum.
-

Anne Frank Huis
Discover the life of Anne Frank at this renowned historic site.
-

BODY WORLDS Amsterdam
Experience the science of the human anatomy at the BODY WORLDS Amsterdam.
-

Beurs van Berlage
Enjoy live entertainment inside this former historic stock exchange building.
-

Bloemenmarkt
Experience the historic floating market, where local vendors sell iconic Dutch tulips.
-

Dam Square
Explore the historic structures of this iconic public square.
-

De Nieuwe Kerk
Discover the Gothic architecture of the De Nieuwe Kerk.
-

De Oude Kerk
Discover the history of this 13th-century church.
-

Eye Film Museum
Discover the heritage of Dutch filmmaking at the Eye Film Museum.
-

Hermitage Amsterdam
Explore Russian art at the Hermitage Amsterdam.
-

Het Concertgebouw
Explore the musical heritage of the Het Concertgebouw.
-

Het Scheepvaartmuseum
Experience the rich maritime heritage of Amsterdam at the Het Scheepvaartmuseum.
-

Hortus Botanicus Amsterdam
Experience the fascinating collection of plant life on display at the historic Hortus Botanicus Amsterdam.
-

House of Bols Cocktail & Genever Experience
Discover the history of Dutch gin distilling at the House of Bols Cocktail & Genever Experience.
-

Houseboat Museum
Explore the history of this refurbished canal freighter from the early 20th century.
-

International Theater Amsterdam
Experience a classical music concert at the historic International Theater Amsterdam.
-

Koninklijk Paleis Amsterdam (Royal Palace Amsterdam)
Explore the official residence of the Dutch Royal Family in Amsterdam.
-

Koninklijk Theater Carré
Discover the Renaissance Revival architecture of this historic theater.
-
Micropia
Experience interesting exhibits about microorganisms at the Micropia.
-

Museum Ons' Lieve Heer op Solder
Discover the history of this intricate 17th-century canal house and church.
-

Museum Van Loon
Explore the wonderful art collection of this stunning 17th-century estate.
-

NEMO Science Museum
Experience interactive science exhibits at the NEMO Science Museum.
-

Pathé Tuschinski
Explore the Art Nouveau and Art Deco architecture at this historic movie theater.
-

Rembrandt House Museum
Discover the legacy of Rembrandt Harmenszoon van Rijn.
-

Rijksmuseum
Explore fascinating artwork from the Dutch Golden Age at this renowned cultural institution.
-

Stedelijk Museum Amsterdam
Experience some of the finest contemporary art in the city at the Stedelijk Museum Amsterdam.
-

Tropenmuseum
Discover photographic art from around the world at the renowned Tropenmuseum.
-

Van Gogh Museum
Explore the art of Vincent Van Gogh at the Van Gogh Museum.
-

Verzetsmuseum Amsterdam
Experience the legacy of World War II in the Netherlands at the Verzetsmuseum Amsterdam.
-

Vondelpark
Discover the verdant nature trails of the 19th-century Vondelpark.
-

Westerkerk
Experience the final resting place of Rembrandt Harmenszoon van Rijn.























